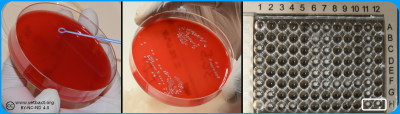
Click to enlarge (opens in a new window). Quality contro

| Contents |
|---|
| Diffusion methods |
| Dilutions methods |
| Enzymes |
| Genotypic methods |
| Quality control |
Before treating bacterial infections, testing of susceptibility is often performed, where the susceptibility of the isolated bacteria to various antibiotics is tested in vitro to provide guidance in the selection of treatment. The tests have to be standardised to be comparable and reliable over time. However, it has to be mentioned that the final result of the treatment depends of various factors, e.g. type and place (organ) of the infection, animal species, immune status of the animal, extension (acute/chronic) of the infection. A number of fenotypic susceptibility tests are available and they are of three fundamentally different types.
Updated: 2024-03-17.
ContentsA bacterial suspension with a tubidity of 0.5 McFarland is spread evenly on a Mueller-Hinton Agar. Antibiotic discs with known concentrations are distributed on the agar. the plate is incubated and then the inhibition zoones are measured - Click on the image to enlarge it.
Image: Theodoros Ntallaris (KV, SLU), Tobi Olaoye (KV, SLU) and Ingrid Hansson (HBIO, SLU).
The disk diffusion method is one of the oldest and most commonly used methods in susceptibility testing. Mueller-Hinton or a modification of the medium is usually chosen for routine susceptibility testing. For weak and slow growing bacteria, modified Mueller-Hinton agar is used with an addition of blood and β-NAD. The plate is inoculated as a lawn of pure culture of the tested bacteria using standardised inoculum. Within 15 minutes of inoculating the agar surface paper discs impregnated with specific concentrations of antibiotics are placed on the agar. The concentrations of the antimicrobial agents in the discs have been chosen to give inhibition zone sizes that correlate with achievable serum levels in the patient.
The plate is incubated in an aerobic atmosphere with the exception of certain fastidious bacteria such as Haemophilus spp. which are incubated in increased CO2 content (5%). The antimicrobial agents immediately begin to diffuse into the medium and are thereby diluted - the further from the disc, the lower concentration.
At the same time, after a short lag phase, the bacteria begin to multiply. Depending on the bacteria´s growth rate, its sensitivity to the antibiotic in question and the antibiotic´s diffusion rate, inhibition zones of different sizes will be observed around the discs. The diameter of the zone is inversely proportional to the MIC value of the strain and with the help of breakpoint tables the bacteria can be categorizes as susceptible (S), intermediate (I) or resistant (R).
Updated: 2024-08-23.
ContentsBacteria (a) are mixed with MilliQ water/NaCl (b) suspension to a turbidity of 0.5 McFarland (c). A part of the suspension (d) are mixed (e) with Mueller-Hinton Broth (f) and inoculated (g) into the wells of the microtitre plate (h), which are covered with plastic film (i) and incubated (j) before determination of MIC value (k). Image: Homayoon Davam, Alva Gustafsson, Ingrid Hanssson (HBIO, SLU). - Click on the image to enlarge it.
In the dilution method, the minimum inhibitory concentration (MIC) of an antibiotic for a bacterium is determined. The method is based on the growth of bacteria on agar or broth with different concentrations of antibiotics in two-fold series in tubes or wells. For practical reasons, commercially available microtiter plates are mainly used in routine diagnostics laboratories where dilution series of different antibiotics are prepared and mostly dehydrated into a microtiter plate with 96 wells. For growth control, two of the wells are usually without antibiotics and used for positive control.
Bacteria whose sensitivity against different antibiotics is to be tested are taken from a pure culture and homogenised with a supsension of ultra clean water or NaCl to obtain a fixed concentration of bacterial suspension, which means a turbidity of 0.5 McFarland. A part of the suspension is then mixed with Mueller-Hinton broth to obtain the desired concentration (104-105 bacteria/ml). For weak and slow growing bacteria, 5% serum is mostly added to achieve the desired growth. Thereafter a standard volume of this bacterial suspension is inoculated in each well and the microtiter plate is sealed with plastic and incubated for the optimal culture conditions of the tested bacteria, such as time, temperature and atmosphere. After incubation, the growth control is visually checked to ensure growth in the wells that do not contain antibiotics. Thereafter, growth or not growth is read in the different wells with antibiotics. In the well with the lowest concentration of antimicrobials that completely inhibits bacterial growth detected by the eye is decided as the MIC expressed in mg/L or μg/ml. To determine the sensitivity of the bacterium, the MIC value obtained is compared with breakpoints (ECOFF) for current antibiotics in of the scientific committees´guidelines for antimicrobial resistance, such as the European Committee on Antimicrobial Susceptibility Testing (EUCAST, https://www.eucast.org/mic_distridutions_and ecoffs).
Another dilution method used for testing susceptibility to antibiotics is the Epsilometer-test (E-test) where the MIC is determined by using gradient strips impregnated with predefined exponential gradient of antibiotic. The bacteria whose susceptibility is to be tested is inoculated as a lawn on an agar plate, usually Mueller Hinton agar with or without blood. After inoculation of the bacterial suspension, the strip with the antimicrobial concentration gradient are immediately places on the inoculated agar and incubated for 18-24 hours. The E-test strip begin immediately to release antibiotics when applied on the inoculated agar plate. After incubation, a symmetrical inhibition ellipse centred along the strip is visible if the bacteria is sensitive to the antibiotic. The MIC is determined where the zone of the inhibition intersect the interpretive scale printed on the strip. If the bacteria is resistant to the tested antimicrobial substance the growth occurs along the entire strip.
Updated: 2025-05-13.
ContentsThere are also rapid methods for testing whether the bacteria carry enzymes that hydrolyse of inhibit specific antimicrobial substances. The enzymes that are routinely tested are the presence of beta-lactamase (penicillinase), which is an enzymes that hydrolyses the beta-lactamase ring in penicillins, which is then inactivated. Beta-lactamase-producing strains for example of Staphylococcus spp. do not always have high MIC values in the microdilution tests which means that further test is needed getting a reliable result such as detection of antibiotic-inactivating enzymes. Several methods are available; two common methods are described below.
The cloverleaf method is a simple and safe way to detect b‑-lactamase production. An agar plate is inoculated with a lawn of a bacterial strain of Staphylococcus aureus susceptible to penicillin. A paper disc impregnated with penicillin (often 10 µg) is placed in the middle of the plate. Radially out from the disc, you streak the strains you want to test for penicillinase production as well as a positive and negative control strains. After one day´s incubation, the susceptible strain can grow further towards the penicillin disc alongside strains producing b‑lactamase because the penicillin around these strains is hydrolysed and inactive. If four positive strains are tested on the same plate, zone of the inhibition will look like a four-leaf clover - hence the name of the method.
Quick method with chromogenic cephalosporins: Cephalosporins have a b‑lactam ring in their structure. Among the various cephalosporins that have been developed, there are some where hydrolysis of the b‑lactam ring causes a color change of the substances, hence he term chromogenic.
NItrocefin is a chromogenic cephalosporin that is commercially available dried on paper discs. The disc is placed directliy on the agar surface in a place with good growth of the bacteria that should be tested. The disc absorbs moisture from the medium and if b‑-lactamase is produced by the bacteria the disc will change color from yellow to red within 30 minutes. It is important that the tests are not performed on media containing blood or serum, since there are substances in serum that cause a false positive reaction. If only culture on blood agar are available, the disc can be placed on a slide and moistened with distilled water, and thereafter colony material could be applied with distilled water, and thereafter colony material could be applied on the disc with a loop. It have to be ensured that the disc does not dry during the 30 minutes that the reaction takes.
Updated: 2024-06-17.
ContentsEven if phenotypic methods are the most frequently used methods in diagnostic laboratories for determining antimicrobial resistance, genotypic methods connecting to identification of resistance genes have been developed. Genotypic (moecular) methods are usually based on conventional PCR (Polymerase Chain Reaction), real-time PCR or whole genome sequencing (WGS). These methods detect the presence of resistance genes or gene mutation that cause a certain resistance mechanism. The weakness of these methods is that they do not necessarily take into account whether the gene is expressed or not, and inaccurate clinical information could be generated.
Updated: 2024-06-17.
Contents
A control of pure culture should be performed after inoculation onto a non-selective agar plate. In the wells of the microdilution plate the last filled wells do not contain antibiotics and are used as positive growth control (Image: Homayoon Davam & Ingrid Hansson, HBIO)- Click on the image to enlarge it.
Regardless of which method is used for susceptibility testing, it is important that analyses are performed according to standardised methods and quality assurance. It is necessary that the bacteria to be tested are in pure culture. In addition, the result is affected by bacterial density, temperature and atmosphere. Most bacteria are tested under the same conditions, but some require other growth media and conditions (Incubation time, temperature and atmosphere). When changing conditions it may be necessary to validate quality control organisms for these test controls.
Microdilution in commercial microtiter plates, should be performed with a bacterial concentration of 104-105 CFU/ml, which is checked by surface spreading of the inoculation broth on a non-selective agar plate such as blood agar. Furthermore, it is important that the microtiter plate is sealed so that no evaporation occurs when testing, since it can increase the concentration of active substance and falsely low values can be maintained. The MIC value is read as the lowest concentration of antimicrobials that completely inhibit bacterial growth. This can be difficult to determine, especially in the case of bacteriostatic substances where there is often a gradual reduction of growth.
For diffusion methods, the zone of inhibition is measured, which can sometimes be difficult to interpret, as the zone boundary can be difficult to assess. An agar plate that is not horisontal, old (=dried out) or too moist allowing some bacteria to swarm can cause incorrect results. Incubation in an anaerobic or microaerophilic atmosphere changes the pH of the medium and thus the diffusion properties. Furthermore, as mentioned, the regression lines are made for bacteria with a high growth rate, the interpretation can be difficult to assess for weak and slow- growing bacteria.
Updated: 2024-06-17.
Contents